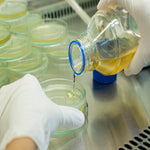

By GMP-SOP-Download Laboratory
USP 61 Total Aerobic Microbial Count
Regular price
£16.99 GBP
Regular price
Sale price
£16.99 GBP
Unit price
per
Tax included.
Shipping calculated at checkout.
Couldn't load pickup availability
SOP for determining the TAMC, formerly known as TVC or Total Viable Count, the quantity of bacteria in a sample according to USP <61> and EP 2.6.12 and to limits stated in USP <1111> and EP 5.1.4
Regular price
£16.99 GBP
Regular price
Sale price
£16.99 GBP